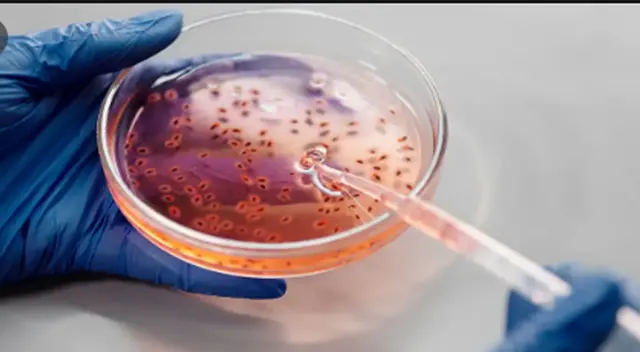
Padres de menor contagiados con difteria. Padres de menor contagiados con difteria.

Padres de niña fallecida por difteria también dieron positivo a la enfermedad
El Hospital Dos de Mayo lamentó la pérdida y se comprometió a seguir apoyando a la familia.
Únete al canal de Whatsapp de El Popular- HABILITARON LINK OFICIAL de la ONPE tras caída: revisa AQUÍ si eres MIEMBRO DE MESA para las Elecciones Generales 2026
- Elecciones 2026: ¿Dónde me toca votar, según ONPE? Conoce tu local de votación y grupo
Luego que se confirmara el deceso de una niña de 5 años por difteria, su padre Liner Agustín Rojas (30) contó las circunstancias en las que habría perdido la vida su hija y al mismo tiempo reveló que él y su esposa dieron positivo a la enfermedad que fue confirmada en nuestro país después de 20 años.
De acuerdo con un comunicado emitido por el Hospital Dos de Mayo, el jueves 29 de octubre la menor recibió el medicamento conocido como antitoxina diftérica que se requiere para tratar la enfermedad. Sin embargo, la pequeña no habría reaccionado bien a este al fármaco pues comenzó a presentar problemas cardíacos.
“Antes de poner el insumo me dijeron que el riesgo era poco, por eso yo confié en los médicos y firmé. Yo como padre la he visto y no había reaccionado como debería ser. Ayer a las 7 de la mañana me informaron que a mi hija le había dado tres paros cardiorespiratorios, uno a las 12 de la madrugada, a la 1 a. m. y a las 4 . m.”, mencionó el deudo.
Mientras tanto, el nosocomio lamento la perdida de la menor. “Lamentablemente, la menor ya había presentado complicaciones cardiacas severas conocidas como “miocarditis diftérica” incluyendo arritmias ventriculares de alto riesgo, los efectos más temidos de esta enfermedad, los que fueron tratados intensivamente por el equipo médico a cargo del caso”.
Cabe mencionar que la hermana de la menor de edad que también era un posible caso sospechoso dio negativo a los exámenes y se encuentra estable. Liner Agustín Rojas pide ayuda a las autoridades para poder darle cristiana sepultura a la mayor de sus hijas . “Solicito al presidente Martín Vizcarra que me apoye en eso, para trasladar a mi hija a la ciudad de Contamana”.